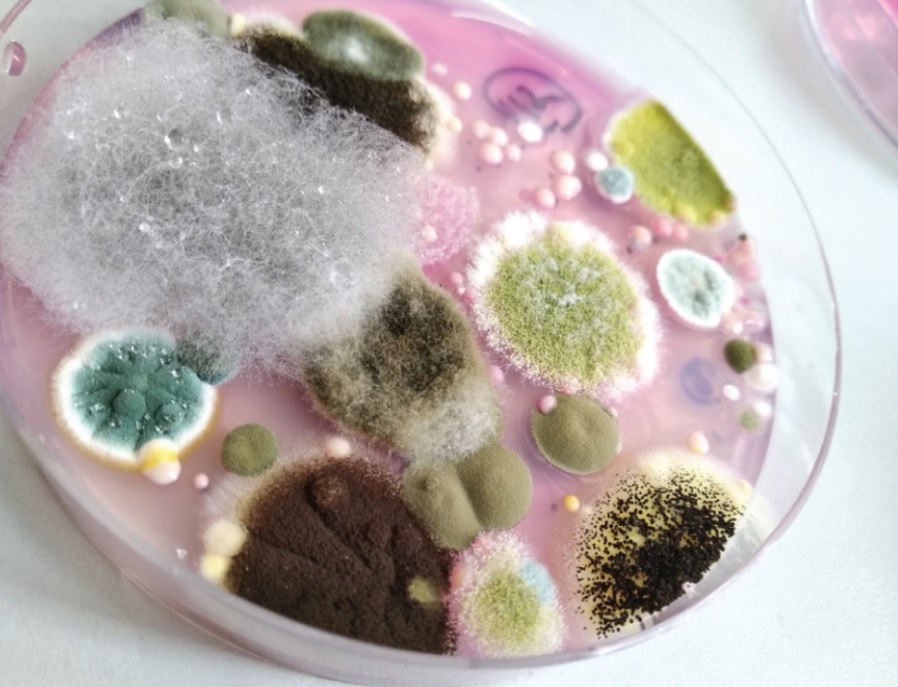

الاقتصادي - آفاق البيئة والتنمية - فراس الطويل
لا يخلو مطبخ فلسطيني من البهارات والتوابل بأصنافها المختلفة، لا سيما أن طعامنا أصبح لا يكتمل من دونها.
لكن هذه البهارات ومع ما تضفيه من نكهة وطعم لوجباتنا، ورغم روائحها الزكية، إلا أنها تخفي أسرارًا خطيرة لا تكشفها سوى مختبرات الفحوص.
أسرار كشفت عنها نتائج دراسة علمية حديثة أُجريت على البهارات في السوق الفلسطينية، وأظهرت تلوثها بفطريات سامة خطيرة تسبب السرطان.
البحث عبارة عن رسالة ماجستير في الأحياء البيئية بكلية العلوم بجامعة بيرزيت، وقد نُشرت الشهر الماضي، في مجلة علمية أميركية متخصصة في نشر المسوحات الخاصة بالأغذية.
أنجزت الدراسة الطالبة سنادي بركات (تعمل حاليا في الولايات المتحدة مديرة ضمان الجودة في منظمة CRO للبحث التعاقدي)، بإشراف د. خالد صويلح، أستاذ علم الأحياء والبيئة في دائرة الأحياء.
حملت الدراسة عنوان "التلوث الفطري، الفطريات الأفلاتوكسينية ومستويات الأفلاتوكسين B1 في التوابل التي تُسوّق في الضفة الغربية".
واستهدفت فحص مستويات السموم الفطرية في سبعة أصناف من البهارات المطحونة في أسواق محافظة رام الله والبيرة، وهي "الفلفل الأحمر، والفلفل الأسود، وبهار الدجاج، والبهارات المشكلة، والهال المطحون، والزنجبيل المطحون، والسماق". وفُحصت (13 – 14) عينة من كل صنف، بما مجموعه 97 عينة لكل الأصناف في مختبرات جامعة بيرزيت.
نتائج صادمة
ركزت الفحوص على ثلاثة جوانب، الأول: الكشف عن التلوث الفطري عمومًا في العينة. والثاني: الكشف عن التلوث الفطري من نوع الأسبيرجيلاس (Aspergillus)، باعتباره من الأنواع المفرزة لسموم الأفلاتوكسين الخطيرة.
والجانب الثالث: الكشف عن كمية الأفلاتوكسين في كل عينة.
أظهرت النتائج تلوث جميع العينات بفطريات مختلفة (ضارة ونافعة) بمعدل يفوق 85 ألف وحدة تكوين مستعمرة فطرية/ غم، علمًا أن الحد الأدنى المسموح به عالميًا هو 10 آلاف وحدة لكل غرام.
25% من العينات كانت ملوثة بنسب تفوق الحدود المسموح بها، وفق الهيئة الدولية للمواصفات الميكروبيولوجية للأغذية (ICMSF).
وجاء في نتائج الدراسة (حصل مراسل آفاق البيئة والتنمية على نسخة منها)، أن 89% من العينات ملوثة بفطر الأسبيرجلاس الخطير، أعلاها في عينات الزنجبيل والبهارات المشكلة، وأقلها في الفلفل الأسود والسماق.
ويذكر أن 82% من فطريات الأسبيرجلاس المكتشفة هي من الأنواع المنتجة للسموم.
وأفاد البحث أن 40% من العينات احتوت على سموم فطرية (أفلاتوكسين B1) الخطيرة، أعلاها في الفلفل الأحمر وبهارات الدجاج والهال المطحون.
ومن تلك العينات التي احتوت سمومًا فطرية خطيرة، كانت 23% منها تحتوي على مستويات سموم أفلاتوكسين بنسب أعلى من الحدود المسموح بها، حسب معايير الاتحاد الأوروبي التي حددتها بـ 5 ميكروغرام لكل كيلو غرام.

جدول يوضح مستويات التلوث الفطري لسبعة أصناف من البهارات
مطالبة بالرقابة
تنتشر الفطريات في كل مكان، وتنمو في الأماكن الرطبة ودرجات الحرارة الدافئة، ويمكن أن تُصاب المحاصيل الزراعية بالفطريات في أثناء الزراعة والنقل والتخزين، بحسب د. خالد صويلح، أستاذ علم الأحياء والبيئة في جامعة بيرزيت.
ويشير صويلح إلى أن الفطريات تكثر في المنتجات الغذائية الواردة من جنوب آسيا، وجنوب شرق آسيا، استنادًا لدراسات عالمية.
تفرز بعض أنواع الفطريات سمومًا شديدة تسمى "الأفلاتوكسينات"، وهي من أكثر الأنواع سمية، وتعد أقوى مادة طبيعية مسرطنة.
وبما أن السموم المذكورة ظهرت في العيّنات المفحوصة في إطار الدراسة، فقد طالب صويلح بضرورة خضوع البهارات والتوابل في الأسواق الفلسطينية للرقابة من قبل جهات الاختصاص، بفحص البهارات التي تدخل باستمرار، وفحص عينات عشوائية دورية من مخازن المحال التجارية لأن "فرص تلوث البهارات بالفطريات السامة عالية".
وأضاف صويلح في حديثه: "نتائج دراسات عالمية أظهرت أن 25% من حالات سرطان الكبد في العالم سببها التعرض للأفلاتوكسينات".
مخاطر أشارت لها منظمة الصحة العالمية في موقعها الإلكتروني، إذ ذكرت أن بعض السموم الفطرية الموجودة في الأغذية (من بينها الأفلاتوكسينات) مرتبطة بآثار طويلة الأجل على الصحة، بما في ذلك السرطان.
بدوره، وعد إبراهيم القاضي، مدير عام الإدارة العامة لحماية المستهلك في وزارة الاقتصاد بسحب عينات من كل أنواع البهارات المبيعة في السوق المحلية ونقلها إلى مختبرات وزارة الصحة لفحصها. وقال القاضي: "الموضوع مهم وهو خطير على الصحة العامة ويستوجب المتابعة الفورية".
وأضاف في حديث مع مراسل آفاق البيئة والتنمية، أن موضوع جودة البهارات ليس جديدا بالنسبة لحماية المستهلك، وكشف عن فحوص أجريت على بهارات تبين أنها كانت مخلوطة بأصباغ حمراء ويتم ترويجها في الأسواق. مشيرا إلى أن جهات الاختصاص احتجزت كميات من البهارات المغشوشة -تقدر بمئات الكيلوغرامات- والآن تتم عملية اتخاذ الإجراءات القانونية.

د. خالد صويلح
منظمة الصحة العالمية:
السموم الفطرية هي مركبات سامة تُنتجها بعض أنواع العفن (الفطريات) إنتاجًا طبيعيًا.
والعفن الذي يمكنه إنتاج السموم الفطرية ينمو على العديد من الأغذية مثل الحبوب، والفاكهة، المجففة، والثمار الجوزية، والتوابل.
ويمكن للعفن أن يتكون إما قبل الحصاد أو بعده، وفي أثناء التخزين، ويمكن أن يتكون على/ في الأغذية نفسها ويحدث ذلك عادة في ظروف الحرارة والبلل والرطوبة.
ومعظم السموم الفطرية مستقرة كيميائياً وتتحمل عملية معالجة الأغذية.
وقد حُدّدت عدة مئات من السموم الفطرية المختلفة، ولكن السموم الفطرية الأكثر شيوعاً والتي تشكل مصدراً للقلق على صحة الإنسان والماشية تشمل: الأفلاتوكسينات، والأوكراتوكسين، والباتولين، والفيومونسنات، والزيارالينون، والنيفانول، والدييوكسي نيفالينول.
وتظهر السموم الفطرية في السلسلة الغذائية نتيجة لتلوث المحاصيل بالعفن قبل الحصاد وبعده.
بعض السموم الفطرية المنقولة بالأغذية لها آثار حادة، ويصاحبها أعراض الاعتلال الوخيم التي تظهر سريعاً بعد استهلاك المنتجات الغذائية الملوثة بالسموم الفطرية.
وترتبط بعض السموم الفطرية الأخرى الموجودة في الأغذية بآثار طويلة الأجل على الصحة، بما في ذلك السرطان.